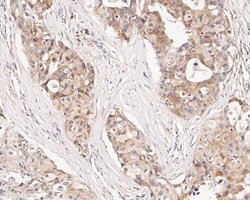
Invitrogen CHRNA3 Polyclonal Antibody 100 &mu;L; Unconjugated:Antibodies,
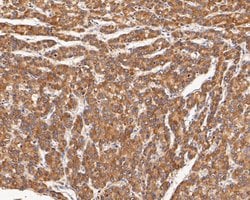
Invitrogen CHRNA3 Polyclonal Antibody 100 &mu;L; Unconjugated:Antibodies,

Learn More
Invitrogen™ CHRNA3 Polyclonal Antibody


Rabbit Polyclonal Antibody
Brand: Invitrogen™ PA5116458
Description
Positive controls: SH-SY5Y cell lysate, Hela cell lysate, human stomach tissue lysate, rat brain tissue lysate, rat testis tissue, human liver carcinoma tissue, human colon carcinoma tissue, human skin tissue, human breast carcinoma tissue, human kidney tissue, human esophagus tissue, human small intestine tissue, human tonsil carcinoma tissue, SH-SY5Y.
CHRNA3 locus encodes a member of the nicotinic acetylcholine receptor family of proteins. Members of this family of proteins form pentameric complexes comprised of both alpha and beta subunits. This locus encodes an alpha-type subunit, as it contains characteristic adjacent cysteine residues. The encoded protein is a ligand-gated ion channel that likely plays a role in neurotransmission. Polymorphisms in this gene have been associated with an increased risk of smoking initiation and an increased susceptibility to lung cancer. Alternatively spliced transcript variants have been described.
Specifications
| CHRNA3 | |
| Polyclonal | |
| Unconjugated | |
| CHRNA3 | |
| (a)3; A730007P14Rik; acetylcholine receptor; Acetylcholine receptor alpha 3 (neuronal nicotine); Acra3; Acra-3; alpha 3; cetylcholine receptor alpha 3 (neuronal nicotine); cholinergic receptor; cholinergic receptor nicotinic alpha 3 subunit; cholinergic receptor nicotinic alpha polypeptide 4; cholinergic receptor, nicotinic alpha 3; cholinergic receptor, nicotinic, alpha 3 (neuronal); cholinergic receptor, nicotinic, alpha polypeptide 3; CHRNA3; LNCR2; nAChR alpha 3; NACHRA3; Neuronal acetylcholine receptor subunit alpha-3; neuronal nicotinic acetylcholine receptor, alpha 3 subunit; neuronal nicotinic acetylcholine receptor, alpha3 subunit; PAOD2 | |
| Rabbit | |
| Antigen affinity chromatography | |
| RUO | |
| 110834, 1136, 25101 | |
| Store at 4°C short term. For long term storage, store at -20°C, avoiding freeze/thaw cycles. | |
| Liquid |
| Flow Cytometry, Immunohistochemistry (Paraffin), Western Blot | |
| 1 mg/mL | |
| PBS with 0.2% BSA, 50% glycerol and 0.05% sodium azide; pH 7.4 | |
| P04757, P32297, Q8R4G9 | |
| CHRNA3 | |
| Synthetic peptide within rat CHRNA3 aa 73-122. | |
| 100 μL | |
| Primary | |
| Human, Mouse, Rat | |
| Antibody | |
| IgG |
Your input is important to us. Please complete this form to provide feedback related to the content on this product.